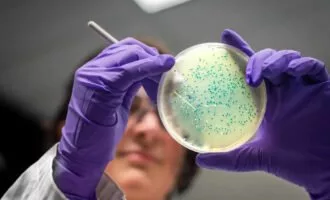
ابرمیکروب‌ها

باکتری
آخرین مطالب
-
سلامت پژوهش جدید: باکتریهای روده کودکان میتوانند بر سلامت روان آنها در آینده تأثیر بگذارند
در این مطالعه به دو گروه باکتری اشاره شده که ممکن است باعث افسردگی کودک در سالهای بعدی زندگی او شوند.
![باکتری های روده انسان]() ۱۱ آبان ۱۴۰۴
۱۱ آبان ۱۴۰۴
-
میان رشته ای رایانههای زنده؛ دانشمندان میخواهند باکتریها را به پردازنده دیجیتال تبدیل کنند
با انجام این کار، دانشمندان قصد دارند از باکتریها برای ساخت زیستحسگرهای هوشمند و رایانههای کممصرف نسل آینده کمک بگیرند.
![پردازنده دیجیتال]() ۲۲ شهریور ۱۴۰۴
۲۲ شهریور ۱۴۰۴
-
سلامت ابتکار جدید دانشمندان: تبدیل زبالههای پلاستیکی به استامینوفن با کمک باکتریهای مدفوع
این دستاورد علمی میتواند زمینهساز توسعه روشهای نوین و پایدار بازیافت پلاستیک شود.
![استامینوفن]() ۴ تیر ۱۴۰۴
۴ تیر ۱۴۰۴
-
میان رشته ای کشف باکتری جدید در آمریکا که مانند یک سیم الکتریسیته را منتقل میکند
محققان باکتری جدید را در گلولای سواحل اورگن آمریکا کشف کردند.
![باکتری و الکتریسیته]() ۱۸ اردیبهشت ۱۴۰۴
۱۸ اردیبهشت ۱۴۰۴
-
میان رشته ای باتری جدید دانشمندان چینی با باکتری کار میکند؛ بازدهی 99 درصدی با قابلیت شارژ خودکار
دانشمندان چینی از باتری زیستی قابلحمل رونمایی کردهاند که بدون نیاز به لیتیوم، با کمک باکتریها شارژ میشود.
![]() ۱۴ اردیبهشت ۱۴۰۴
۱۴ اردیبهشت ۱۴۰۴
-
میان رشته ای ابداع محققان MIT: باکتریهای مهندسیشده وضعیت خاک را از راه دور به پهپادها نشان میدهند
از کاربردهای این فناوری میتوان در صنعت کشاورزی برای نظارت بر سطح نیتروژن و دیگر مواد مغذی خاک اشاره کرد.
![باکتریهای مهندسیشده]() ۲۵ فروردین ۱۴۰۴
۲۵ فروردین ۱۴۰۴
-
سلامت دستاورد محققان: روش جدیدی که تشخیص زودهنگام عفونت را ممکن میسازد
روش جدید تشخیص توالی DNA باکتریها میتواند سالانه هزاران نفر را نجات دهد و از ظهور ابرمیکروبها جلوگیری بهعمل آورد.
![ابرمیکروبها]() ۱۷ اسفند ۱۴۰۳
۱۷ اسفند ۱۴۰۳
-
سلامت محققان: بوسیدن میتواند تا ۸۰ میلیون باکتری را بین دو نفر منتقل کند
به گفته محققان هلندی، بوسیدن به مدت 10 ثانیه میتواند 80 میلیون باکتری را بین 2 نفر منتقل کند.
![بوسه و باکتری]() ۲۹ دی ۱۴۰۳
۲۹ دی ۱۴۰۳
-
میان رشته ای محققان: موجودات و باکتریهای آینهای میتوانند در آینده برای انسان کشنده باشند
محققان میگویند در یک دهه آینده احتمالاً باکتریهای آینهای در آزمایشگاهها ایجاد میشوند و برای انسان خطرناک خواهند بود.
![باکتریهای آینهای]() ۳ دی ۱۴۰۳
۳ دی ۱۴۰۳
-
علمی مطالعه جدید دانشمندان: دوستان صمیمی حتی باکتری روده مشابهی دارند
شباهت بین شما و دوستانتان می تواند فراتر از خصوصیات اخلاقی و شخصیتی باشد. براساس مطالعه ای جدید این شباهت می تواند باکتری های پوشاننده ...
![]() ۹ آذر ۱۴۰۳
۹ آذر ۱۴۰۳
-
میان رشته ای مطالعه جدید: باکتریهای داخل دهان به یک روش عجیب و نادر تولیدمثل میکنند
شکافت چندتایی باکتری سی. ماتروکوتی توضیح میدهد که چرا پلاکهای دندان چند ساعت بعد از مسواک زدن دوباره ظاهر میشوند.
![تولیدمثل باکتری های پلاک دندان]() ۱۵ شهریور ۱۴۰۳
۱۵ شهریور ۱۴۰۳
-
میان رشته ای این جانداران ریز از ژن باکتریها برای تولید آنتیبیوتیک و مبارزه با بیماریها استفاده میکنند
دانشمندان عقیده دارند که موجوداتی موسوم به «چرخانتباران» میتوانند راهی برای تولید آنتیبیوتیکهای ایمنتر برای انسانها و حیوانات به ما نشان دهند.
![چرخان تباران]() ۳۱ تیر ۱۴۰۳
۳۱ تیر ۱۴۰۳
-
انرژی دستاورد محققان: باتری جدیدی که انرژی خود را از درون خاک تأمین میکند
این باتریها میتوانند در تأمین انرژی ارزان و پاک در کشاورزی سودمند واقع شود.
![باتری و باکتری]() ۳۰ خرداد ۱۴۰۳
۳۰ خرداد ۱۴۰۳
-
سلامت کشف باکتریهای خونآشام مرگباری که جذب خون میشوند
در آزمایشهایی که برای مطالعه انجام شد، کمتر از یک دقیقه طول کشید تا باکتریهای خونآشام متوجه شوند که خون در آن نزدیکی است.
![]() ۳۰ فروردین ۱۴۰۳
۳۰ فروردین ۱۴۰۳
-
هوش مصنوعی دستاورد محققان: هوش مصنوعی مولدی که میتواند آنتیبیوتیکهای جدید طراحی کند
هوش مصنوعی مولد «SyntheMol» میتواند آنتیبیوتیکهای جدیدی برای مقابله با باکتریهای خطرناک طراحی کند.
![هوش مصنوعی و آنتیبیوتیک]() ۵ فروردین ۱۴۰۳
۵ فروردین ۱۴۰۳
-
میان رشته ای محقق MIT توانست بازی Doom را با باکتریهای روده اجرا کند!
بازی محبوب Doom روی پلتفرمهای عجیب و مختلف زیادی اجرا شده، و حالا یک محقق بهسراغ اجرای آن روی باکتریهای روده رفته است.
![اجرای بازی Doom با باکتری روده]() ۱۶ بهمن ۱۴۰۲
۱۶ بهمن ۱۴۰۲
-
سلامت کشف محققان با کمک هوش مصنوعی: ترکیباتی که باکتریهای مقاوم به دارو را از بین میبرند
باکتریهای مقاوم به آنتیبیوتیک هرساله باعث مرگ میلیونها نفر میشوند؛ حالا هوش مصنوعی ترکیباتی را پیدا کرده است که میتواند به کمک ما بیاید.
![باکتری]() ۲ دی ۱۴۰۲
۲ دی ۱۴۰۲
-
علمی دانشمندان با مهندسی باکتریها، دو محصول ارزشمند از فیبر گیاهی تولید میکنند
اکنون محققان دانشگاه ویسکانسین-مدیسون باکتریهایی را مهندسی کردهاند که میتوانند همزمان دو محصول شیمیایی را از الیاف گیاهی کممصرف تولید کند.
![]() ۱ دی ۱۴۰۲
۱ دی ۱۴۰۲
-
علمی مطالعه جدید: برخی از باکتریهای روده میتوانند به بهبود سلامت روان کمک کنند
باکتری لاکتوباسیلوس با کنترل پروتئینهای سیستم ایمنی واکنشهای مغز را در محیطهای استرسزا تنظیم میکند.
![نقش باکتری های روده در سلامت روان]() ۱۰ آذر ۱۴۰۲
۱۰ آذر ۱۴۰۲
-
سلامت برای اولینبار ارتباط بین میوهها، سبزیجات و میکروبیوم در تحقیق جدیدی تأیید شد
به گفته دانشمندان، باکتریهای مربوط به میوه و سبزیجات بهطور متوسط 2.2 درصد از تنوع کل باکتریهای ما را تشکیل میدهد.
![میکروبیوم]() ۶ آبان ۱۴۰۲
۶ آبان ۱۴۰۲

همچنین میتوانید جهت آگاهی از آخرین اخبار در حوزه تکنولوژی و اطلاع از بروزرسانی دیجیاتو مارا در شبکههای اجتماعی زیر نیز دنبال کنید. خوشحالیم که همراه ما هستید.